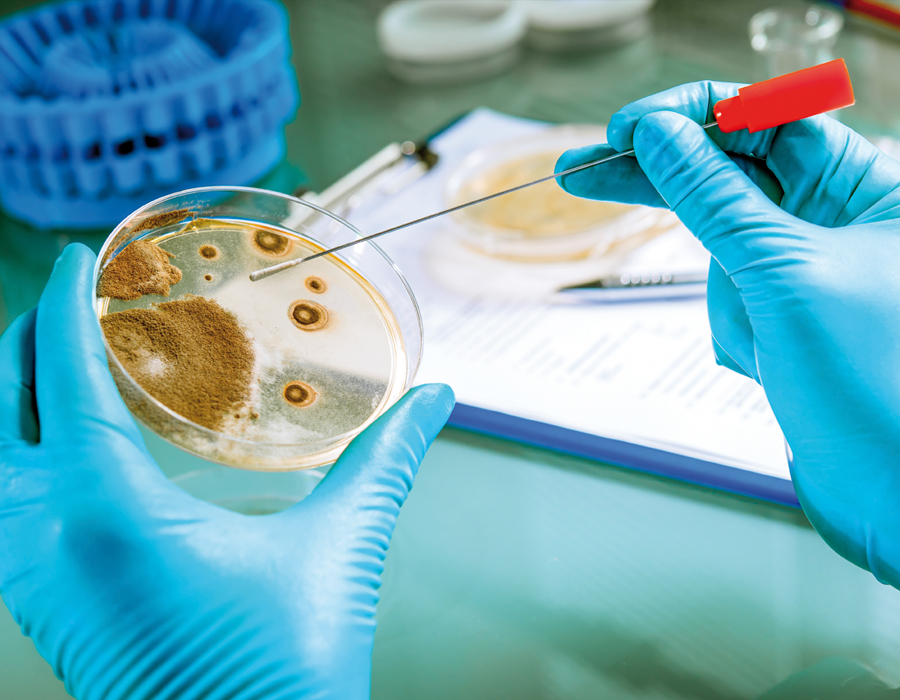

Unsere Themen
- Ferdinand Sauerbruch
- Was sind Viren?
- Die Charité
- Albert Schweitzer
- Penicillin
- Allopathie / Homöopathie
- Hausmittelchen: Salzstangen und Cola,
- Wadenwickel, Zwiebel aufs Ohr etc.
- Medizinische Missverständnisse und
- Ammenmärchen
- Historische Medizin im alten Ägypten,
- im antiken Rom
- Aberglaube: Haifischflosse & Nashornhorn
- als Potenzmittel
- Impfen – wie wirkt das?
- Skorbut – die Krankheit der Seefahrer
- Rachitis – die Krankheit der industriellen
- Revolution
- Berufskrankheiten
- Sigmund Freud
- Tuberkulose
- Julius Cäsar, Epileptiker
- Karl Friedrich Schinkel
- An apple a day keeps the Doctor away:
- medizinische Volksweisheiten
- Helmut Schmidt und andere
- medizinische Phänomene
- Heilkräuter
- Hygienemuseum in Dresden
- Hygiene
- Immunsystem
- Pharmaziestudium
- Medizinstudium
- Wer war Äskulap? Was symbolisiert der Äskulapstab?
- Visionäre Medizinideen & Zukunftsdenken
- Transplantationen
- Organe aus dem 3-D-Drucker
- Modell: Was macht ein Pollen auf einer Schleimhaut? Was ist eine Allergie?
- Viel trinken! Thema: Wasser
- Multiresistente Krankenhauskeime
- Kosmetik & Spa
- Geschichte der Schönheitschirurgie
- Scharlatanerie: Haarwuchsmittel etc.
- Aphrodisiaka
- Historische Krankheiten:Spanische Grippe, Pest etc.
- Haustiere und Mensch: Welche Krankheiten können übertragen werden?
- Heilkraft der Natur
- Medizin der Ureinwohner Brasiliens
- Medizin der Ureinwohner Australiens
- Rückenschmerzen
- Apotheker – der Beruf
- Meine Reiseapotheke
- Meine Hausapotheke
- Meine Autoapotheke
- Gegenüberstellung historischer und gegenwärtiger Pharmazieverpackungen
- Gegenüberstellung historischer und gegenwärtiger Pharmaziewerbung
- Entwicklung und Historie des Apotheken-Logos
- Zecken
- Risiken und Nebenwirkungen:Alle Medikamente haben Nebenwirkungen
- Akupunktur
- Apothekerin und Apotheker:persönliche Beratung statt Online-Apotheke
- Buchempfehlungen: Gesundheit
- Tee
- Hepatitis
- Geschlechtskrankheiten – früher und heute
- Warum werden meisten pharmazeutischen
- Produkte inzwischen in Asien produziert?
- AIDS ist nicht vorbei
- Potenzmittel, auch historisch gesehen
- Verhütungsmittel, auch historisch gesehen
- Ernährung – vegetarisch, vegan etc.
- Florence Nightingale
- Kriegslazarette: Medizin auf Minimalniveau
- Gesundheitsprobleme der Zukunft, z. B. durch Bewegungsmangel,Bildschirmarbeit, Stichwort: Sitzen ist das neue Rauchen
- Wann kühlen, wann wärmen?
- Richtig Zähne putzen
- Der Rettungssanitäter
- Der Unfallchirurg
- Der Ersthelfer
- So wichtig ist ein Erste-Hilfe-Kurs
- Wie härte ich meine Körper ab? Im Winter im Rhein schwimmen – oder lieber in die Sauna?
- Insektensterben
- Wie gefährlich ist Schimmel?
- Wie schütze ich mich vor UV-Einstrahlung richtig? Gefahr durch Sonne
- Warum werden Japaner so alt?
- Hypochondrie
- Psychosomatik
- Spenden (Blut, Plasma, Organe etc.)
- Selbst gemachte Naturkosmetik
- Blutgruppendiät
- Wunderheiler
- Entgiftung und Entschlackung
- Die Haut als größtes Organ
- Wetterfühligkeit und Mondphasen
- Was ist Fieber?
- Organsprache: „Zu viel um die Ohren haben“,
Unsere grafisch individuell gestalteten Themenausstellungen haben immer einen relevanten Hintergrund und eine wichtige Botschaft. In erster Linie werden medizinische und pharmazeutische Sachverhalte und Phänomene kommuniziert. Dabei bleiben aktuelle globale sowie auch lokale, kulturelle, philosophische, ethische, politische, soziale und ökologische Fragen, wie z.B. Nachhaltigkeit, Klima- und Umweltschutz, nicht unberücksichtigt.
Der besondere Service für Apotheken
Zu sämtlichen Ausstellungen gibt es gut verständliche Erläuterungstexte, kompakt zusammengefasst auf einer Din-A4-Seite, die kostenlos in Ihrer Apotheke zur Abholung bereitliegt. Darüber hinaus haben Sie die Möglichkeit, die Texte und Ausstellungen immer auch auf Ihrer Website und in Ihren Social-Media-Kanälen zu präsentieren.
Das Bewusstsein für Gesundheit ist nicht nur ein Thema für die ältere Generation. Informationsbedarf gibt es in jedem Alter. Mit Ihrer individuellen Schaufensterausstellung haben Sie als Apotheke die Möglichkeit, zu informieren, aufzuklären, zu unterhalten und viele Fragen zu klären.
Wir haben eine vielseitige Auswahl mit interessanten Themen für jeden Lebensabschnitt zusammengestellt.